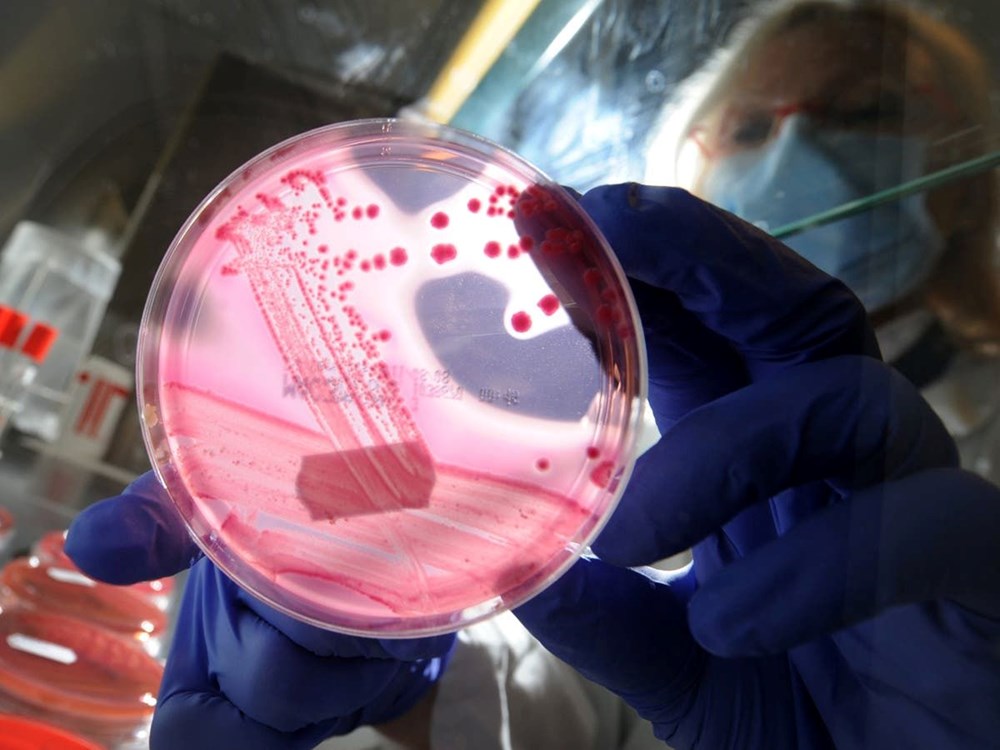

Rusya’da hükümet, ülkenin Arktik bölgelerindeki permafrostun erimesinin antik ve ölümcül virüs ile bakterileri serbest bırakabileceği konusunda uyardı. Kuzey Kutbu Konseyi'ne başkanlık eden üst düzey diplomat Nikolay Korchunov, küresel ısınma nedeniyle toprak çözülürken on binlerce yıl boyunca donda kalan mikropların 'uyanma' riskinin olduğunu söyledi. Korchunov. konuya ilişkin yetkililerin önlem almaya başladığını kaydederken, Sibirya'daki anormal hava sıcaklıkları endişe veren boyutlarda artış göstermeye devam ediyor.
Dünya küresel ısınma nedeniyle adım adım sona yaklaşırken Rusya'dan çok önemli bir uyarı geldi. Rusya Kuzey Kutbu Konseyi Başkanı Nikolay Korchunov, Sibirya'daki kalıcı buzların erimesinin dünya için çok ciddi sonuçları olacağını açıkladı.
Nikolay Korchunov, konseyin en azından son buzul çağından bu yana donmuş olabilecek hastalıkların yeniden ortaya çıkmasının yol açtığı riskleri ve olası etkileri incelemek için bir "biyogüvenlik" projesi oluşturduğunu söyledi.

BİYOGÜVENLİK PROJESİ BAŞLATILDI
Rus Zvezda televizyonuna konuşan Korchunov, "Eski virüs ve bakterilerin uyanma riski var.
Bu nedenle Rusya, Arktik Konseyi bünyesinde bir biyogüvenlik' projesi başlattı. Proje, 'permafrost bozulması' ve 'gelecekteki bulaşıcı hastalıklar' ile ilgili 'risk ve tehlikeleri' değerlendirmekle görevlendirilecek” dedi.

PERMAFROST NEDİR?
Bununla birlikte, Rusya topraklarının yaklaşık yüzde 65'i, yaz aylarında bile kalıcı olarak donmuş kalan toprak yani permafrost olarak sınıflandırılıyor. Ancak, küresel ısınma nedeniyle sıcaklıklar arttıkça, yer artık çözülmeye başlıyor ve binlerce yıldır donmuş olan hayvan ve nesne kalıntıları ortaya çıkıyor.

Yaklaşık 14 bin yıl önce soyu tükenmiş yünlü gergedanların kalıntıları ve 40 bin yıllık bir kurt kafası (o kadar mükemmel korunmuş ki hala kürkü vard) son yıllarda gün ışığına çıkarıldı.

Avcılar, dişlerini çıkarıp fildişi tüccarlarına satabilmek için gün yüzüne çıkarılan iskeletleri aramaya çıktıkça, soyu yaklaşık 10 bin yıl önce tükenmiş olan yünlü mamutlara bağımlı bir endüstri bile ortaya çıkardı.

Ancak böyle iyi korunmuş örneklerin keşfi, hayvanların taşımış olabileceği hastalıkların onlarla birlikte çözülebileceği ve ev sahiplerinin aksine, hastalıklarının çözülerek hayatta kalabileceği korkusuna yol açtı.

Fransa’da yer alan Aix-Marseille Üniversitesi'nden bir virolog olan Jean Michel Claverie, eriyen derin permafrosttaki bakterilerin canlanabileceği konusunda geçen yıl son derece güçlü kanıtlar bulunduğu konusunda uyardı.
HALİ HAZIRDA BÖLGEDEKİ ANTİK BİR VİRÜS KEŞFEDİLDİ
Profesör Claverie, permafrosttan çözüldüğünde amiplere saldırmaya ve öldürmeye başlayan pithovirus adlı bir patojeni keşfetti.

Deneyden önce yaklaşık 30 bin yıl boyunca donmuş olan pithovirüs, insanlara zararsız olsa da, Profesör Claverie, bunun uzun süredir donmuş virüslerin "uyanabileceğini" ve konakçıları yeniden enfekte etmeye başlayabileceğini gösterdiğini söyledi.

Diğer taraftan, bilim insanları Kuzey Kutbu buzulunun kesin yaşı, onu çevreleyen permafrost ve dolayısıyla içerdiği nesnelerin yaşı konusunda anlaşamıyorlar. Ancak şimdiye kadar ortaya çıkarılan çoğu nesne , yaklaşık 115 bin ile 11 bin 700 yıl önce yaşanan Son Buzul Çağı’ndan kalma.

KARBONDİOKSİT VE METAN GAZI TEHLİKESİ
Tüm bunların yanı sıra bilim insanları, permafrost eriyiğinin içinde tutulan organik madde çürümeye başlarken, karbondioksit ve metan gazlarının salınımı nedeniyle daha da büyük bir tehdit oluşturduğu konusunda uyardı.

Her iki gaz da küresel ısınmaya katkıda bulunarak, dünyadaki buzul erimesinin hızlanmasına neden oluyor. Geçen yıl Kuzey Kutup Dairesi'ndeki büyük bir petrol sızıntısı, etrafındaki zemin çökmesinin ardından erimeden sorumlu tutuldu.

PUTİN DE UYARMIŞTI
Rusya Devlet Başkanı Vladimir Putin ise ülkenin kuzeyinde permafrost erimesi ve daha genel olarak küresel ısınma tehdidi hakkında giderek daha fazla yorumda bulunuyor.
Geçen yıl bir konferansta konuşan Putin, “Yaklaşık üç veya dört metre olan permafrostun yüzeye yakın katmanlarının yüzde 25 kadarı 2100 yılına kadar erirse, etkiyi çok güçlü bir şekilde hissedeceğiz. Bu durum, boru hattı sistemlerini ve permafrost üzerine inşa edilmiş yerleşim bölgelerini etkileyecek” demişti.
Yorum Gönder